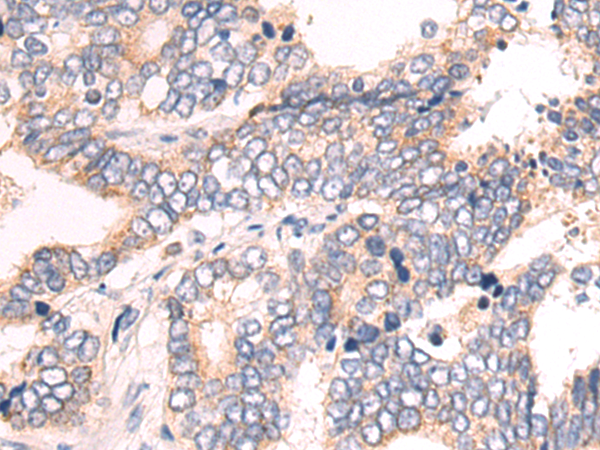

-
分类: 科研抗体货号: P09203别名: YWHAS应用: WB,IHC反应种属: Human, Mouse
-
分类: 科研抗体货号: P09218别名: ZN473; ZFP100应用: WB,IHC反应种属: Human, Mouse
-
分类: 科研抗体货号: P09192别名:应用: IHC反应种属: Human, Mouse
-
分类: 科研抗体货号: P09201别名: F25965; lin-37; ZK418.4应用: IHC反应种属: Human, Mouse
-
分类: 科研抗体货号: P09217别名:应用: WB,IHC反应种属: Human, Mouse
-
分类: 科研抗体货号: P09190别名:应用: WB,IHC反应种属: Human, Mouse
-
分类: 科研抗体货号: P09233别名: FPM315; ZSCAN44; ZKSCAN12应用: WB,IHC反应种属: Human
-
分类: 科研抗体货号: P09215别名: MPDS; CDGIE应用: IHC反应种属: Human, Mouse
-
分类: 科研抗体货号: P09189别名: SDR45C1应用: WB,IHC反应种属: Human, Mouse, Rat
-
分类: 科研抗体货号: P09232别名: ZNF259应用: WB,IHC反应种属: Human, Mouse

鄂公网安备42018502007531号
鄂公网安备42018502007531号

